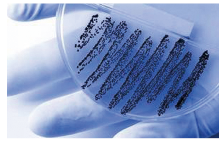

安徽医科大学叶冬青教授等一项Meta分析显示,在14种新型或经典幽门螺杆菌(H.pylori)感染治疗方案中,既往推荐的7 d标准三联疗法有效性最低。(BMJ.2015年8月19日在线版)
目前,哪种H.pylori治疗方案最有效、耐受性最强尚不明确。该研究纳入143项试验,3.2万余例患者进行有效性分析,2.2万余例患者被纳入耐受性分析。
研究者分析了14种经典或新型治疗方案,结果显示,其中6种方案疗效明显优于标准三联疗法(质子泵抑制剂联合克拉霉素和阿莫西林或甲硝唑,联用7 d)。分别为7 d伴随治疗,即质子泵抑制剂(PPI)联合3种抗生素(RR=1.29)、10 d或14 d伴随治疗(RR=1.24)、10 d或14 d标准三联治疗联合益生菌(RR=1.24)、10 d或14 d以左氧氟沙星为基础的三联治疗(同时使用PPI、左氧氟沙星和另一种抗生素,RR=1.23)、14 d杂交治疗(连续7 d同时使用PPI和阿莫西林,然后连续7 d同时使用PPI、阿莫西林、克拉霉素和5-硝基咪唑)(RR=1.22)、10 d或14 d序贯治疗(5~7 d同时使用PPI、阿莫西林,后5~7 d同时使用PPI、克拉霉素、5-硝基咪唑或阿莫西林,RR=1.20)。
大多数病例中,治疗时间越长,效果约好,但耐受性差。尽管所有治疗方案均可耐受,但7 d三联治疗联合益生菌以及7 d左氧氟沙星为基础的三联治疗耐受性最好。